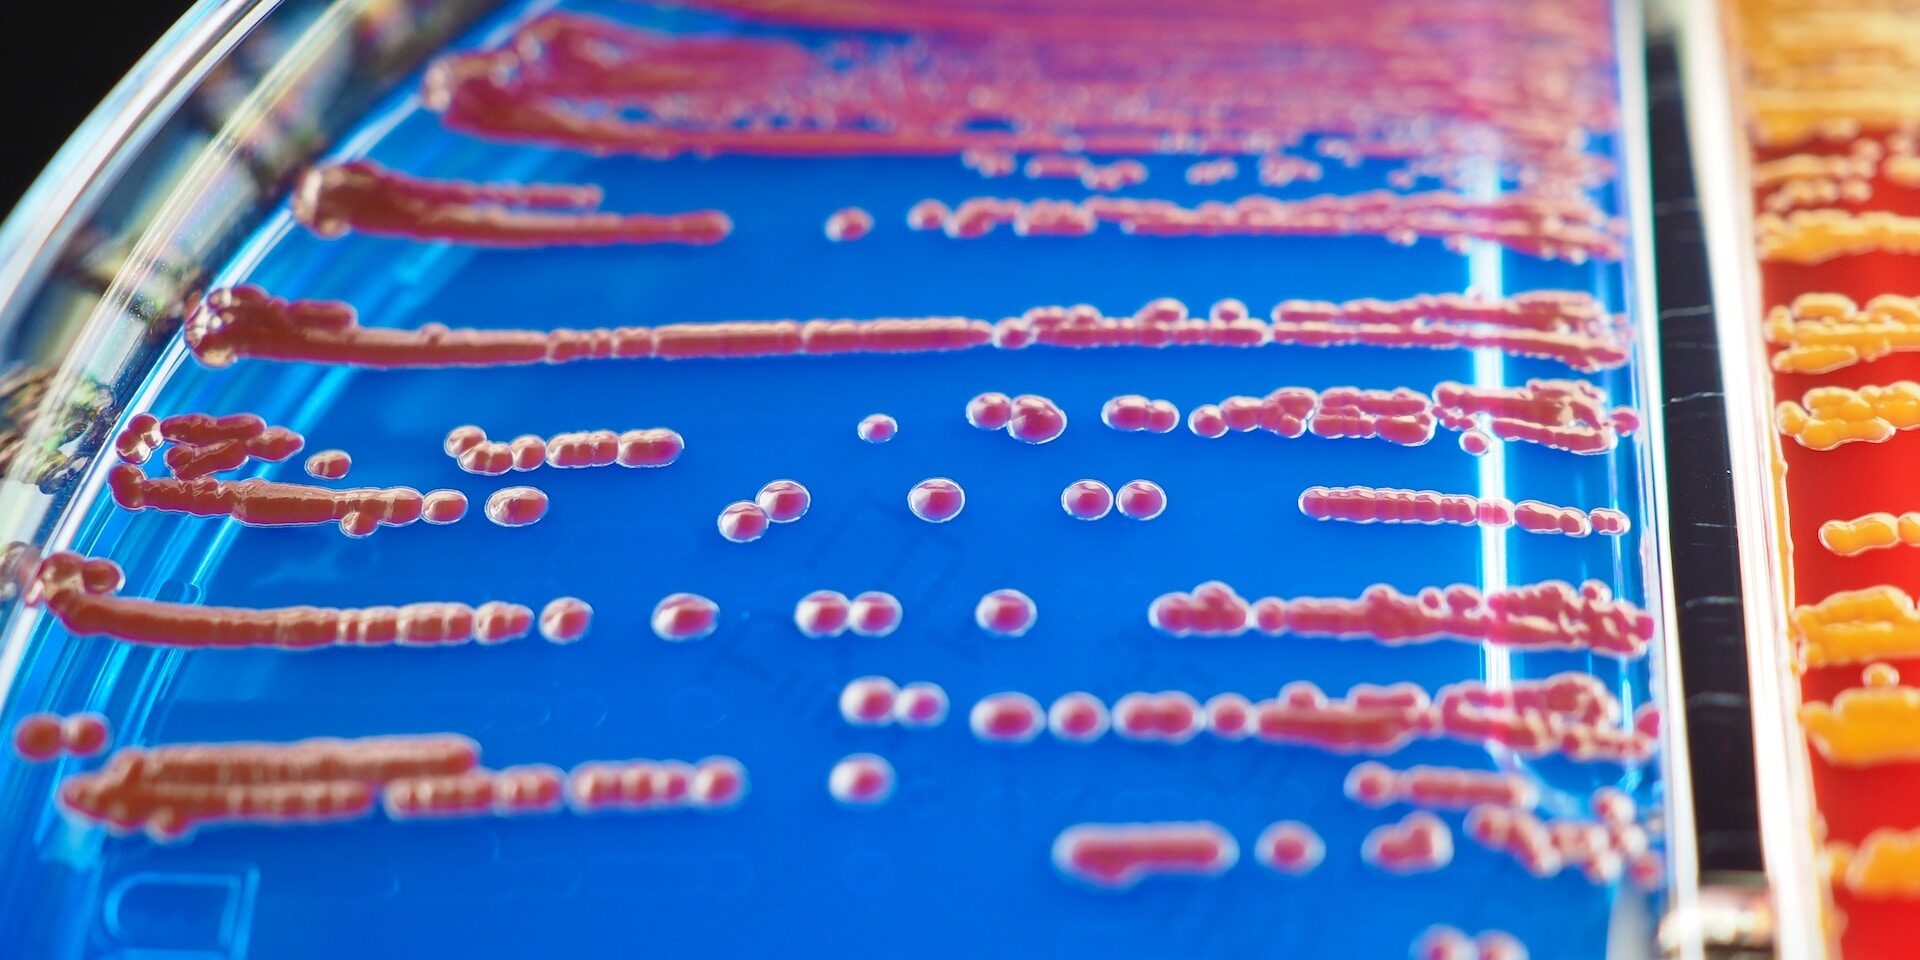

I microbi: come proteggerci dal contagio indiretto
Durante la recente pandemia, tre Dipartimenti dell’Università di Cagliari hanno collaborato a una ricerca che ha portato alla domanda di brevetto per un rivestimento antimicrobico per superfici. Per parlare di questi risultati, porteremo esempi di varie superfici di uso comune disposte sul tavolo in ordine casuale. Saranno preparate (e messe in sicurezza) delle piastre in cui saranno seminati i campioni raccolti realmente da queste superfici e chiederemo ai partecipanti di abbinare le superfici con le piastre in ordine di contaminazione e associare delle immagini al microbo a cui appartengono. Spiegheremo le caratteristiche dei principali disinfettanti in commercio e la loro azione sui microbi.
Saremo in grado di dimostrare in maniera molto semplice come mai uno agisca su un microrganismo e non sull’altro e l’importanza di usare la cosa giusta al momento giusto. Questo percorso porterà alla riflessione sul concetto di resistenza di microrganismi sulle superfici, di contagio indiretto e della possibilità di prevenzione tramite rivestimenti antimicrobici. Presenteremo infine dei provini di varie superfici trattate con il rivestimento antimicrobico (che potrà essere toccato con mano) e la ricerca che ha portato a questa scoperta.
Laboratorio interattivo visitabile senza prenotazione dalle ore 16 alle 23.
A cura di Silvia Puxeddu, medico specializzando in microbiologia e virologia (Dipartimento di Scienze Biomediche).
Descrizione foto: un’immagine ingrandita di microbi in laboratorio.
Foto di masakazu sasaki su Unsplash